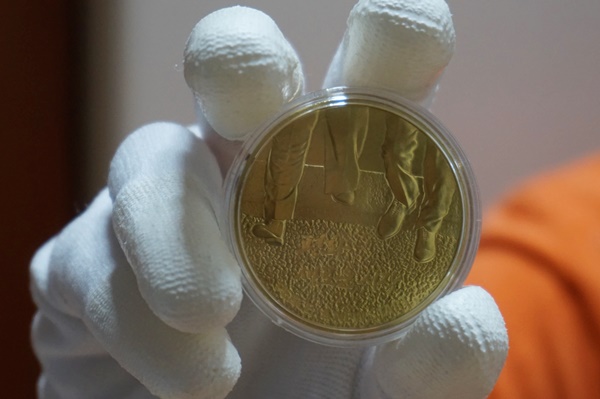

드디어 다 모은 용돈을 들고 은행으로 향했던 초등학교 4학년 아들! 열심히 심부름도 하고 아끼고 아껴 모은 3만2천 원을 들고, 유난히 무더웠던 7월 여름방학 중에 엄마까지 대동해서 가까운 은행으로 향했습니다. 초등학생 아들은 미리 전화로 다 알아봤다고, 엄마의 신분증을 꼭 가지고 가야 한다며 저를 재촉했습니다.
 |
한반도 평화 기념메달 황동화. |
사실 여름방학 때 몇 번이나 아침 9시면 은행 고객센터로 전화한 초등학생은 저의 아들이 유일하지 않을까 생각합니다. 아직까지 제겐 이름도 헷갈리는 그 ‘한반도 평화 기념메달’ 예약 접수를 하러 은행에 갔던 날, 또 그 메달이 9월 17일 도착했다는 안내 전화를 받던 날, 아들의 표정을 잊을 수가 없습니다.
사실 본인이 모은 돈이라고 하더라도 분명한 목적과 이유가 있어야 용돈을 사용할 수 있는 우리 집 상황에서 3만2천 원짜리 황동화 한 개를 구매하려면 많은 어필을 해야 했습니다.
아들은 지금까지 모은 남북정상회담, 북미정상회담 관련 자료들을 수시로 인터넷에서 찾아 보여주며 이것은 평화를 위한 큰 발걸음이기 때문에 의미가 커서 소장 가치도 높다며 계속 설명과 설득을 반복했습니다.
남북정상회담에 이은 남북 평화무드가 매우 가치와 의미가 있다고 생각했기에 허락은 했습니다. 하지만 이렇게 초등학생 아들의 전 재산을 털어 넣을 만큼의 의미가 있었는지는 잘 몰랐던 게 사실입니다.
 |
고구려 고분벽화 기획전시가 열렸던 한성백제박물관 앞에서. |
요즘 아이들의 꿈에 대해서 들어보면 1인 크리에이터, 아이돌, 연예인 등이 많은데요, 특이하게 저의 둘째 아이는 역사와 문화재를 좋아해 역사학자 또는 역사 스토리텔러라고 합니다. 지난해 한성백제박물관에서 했던 기획전시에서 고구려 고분벽화 전시를 보러 갔던 기억이 납니다.
아이는 우리나라에서 볼 수 없는 고구려 고분벽화 기획전시라는 점에서 직접 해설사께 질문도 많이 했었습니다.
북한에 있었던 고구려 고분벽화를 어떻게 우리나라에서 전시할 수 있었는지에 대한 아들의 질문에 해설사는 남북 교류가 활발하던 시절에 남한과 북한의 역사 문화재 자료들이 서로 공유가 되었다는 설명을 들었습니다.
 |
한성백제박물관 고구려 고분벽화를 VR로 직접 둘러보는 초등학교 3학년 아들. |
그날 VR로 고구려 고분벽화를 둘러보며 당시 초등학교 3학년이었던 아들은 꼭 한반도에 평화가 찾아와서 북한의 문화재를 직접 보고 싶고, 잘 보존하여 지키는 일을 하고 싶다는 생각까지 품기 시작했습니다.
그런데 나라에서도 이런 아들의 간절한 마음을 알았던 걸까요? 시대의 흐름이 한반도 평화무드로 바뀌면서 휴전 이래 북미정상회담, 3차 남북정상회담과 대통령의 UN 총회 연설까지 한창 꿈 많은 초등학교 4학년 아들의 마음을 설레게 하는 일들이 연속해서 일어나고 있습니다.
역사와 문화재를 사랑하는 아이의 마음에 ‘한반도 평화’라는 키워드가 더해지면서 아이의 꿈은 일상 속 가족의 대화 판도를 바꿔놓고 있습니다.
늘 4차 산업 혁명 시대에 나는 역사와 문화재를 위해 어떤 일을 해야 할까 고민하는 아들에게는 이번 평화가 더 반갑다고 합니다.
.JPG) |
한성백제박물관에서 본 안악 3호분 축소모형. |
북한의 국보 문화유물 1호는 ‘평양성’이라고 아들이 얘기해줬는데요. 유네스코 세계문화유산으로도 등록된 고구려 벽화 고분인 약수리 벽화무덤(29호), 수산리 벽화무덤(30호), 안악 3호분(67호) 등도 국보 문화유물로 지정되어 있다는 것을 이번 기회에 찾아보며 알게 되었다고 합니다.
특히 안악 3호분은 한성백제박물관 고구려 고분벽화 전시 때 봤었던 것이라 더 애정이 가고 실제로 보고 싶은 큰 바람을 가지고 있습니다.
무엇보다 북한의 문화재 보존과 관리가 궁금한 아들은 미래의 꿈을 위해 북한의 문화재를 볼 기회를 주었으면 좋겠다고 이야기합니다. 동생의 이런 이야기를 들으며 누나는 “아직 먼 얘기다” 라며 투닥투닥 다투는 게 요즘 우리집의 일상입니다.
|
한반도 평화 기념메달 황동화 뒷면. |
우리의 일상 속 대화가 되어버린 한반도의 평화! 아이들에게는 실제적으로 자신의 꿈을 이루고 직업을 갖게 될 다양한 소재가 된다는 생각에 변화하고 있는 한반도의 평화무드가 즐거운 기대감을 안겨주고 있습니다.
이런 아이의 간절한 꿈이 평화의 바람을 맞아 한반도로 또 확장되는 것을 보면서 엄마인 저 또한 한반도의 미래가 궁금해집니다. 4차 산업혁명 시대에 기계가 하는 일 외에는 할 일이 없다고 낙담하는 가운데 저의 아들에게는 그저 이 한반도 평화가 자신의 꿈을 이루어주는 소재가 될 거라며 들떠있는 모습이 아이다운 순수함으로 느껴져서 보기 좋습니다.
 |
한반도 평화 기념메달 황동화 앞면을 보이며 미소짓고 있는 아들. |
오늘도 자신의 꿈을 이루어줄 한반도의 평화를 바라보며 열심히 한반도의 역사 문화재를 찾고 있는 아들의 꿈을 우리 가족들도 함께 열렬히 응원합니다!
대한민국 정책기자단 조성희 purejoy@naver.com